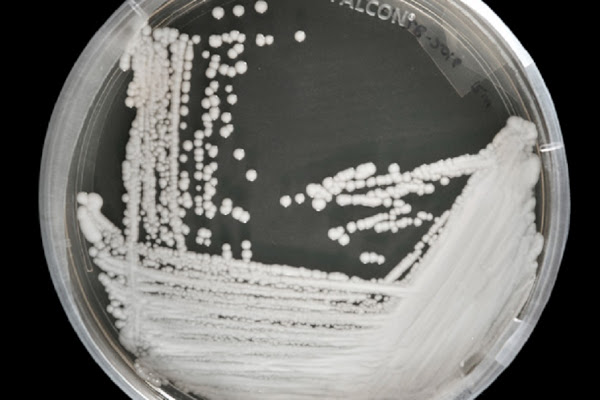
Candida auris, la diffusione del fungo killer colpa dei cambiamenti climatici?

Candida auris, la diffusione del fungo killer colpa dei cambiamenti climatici?
di Redazione
25/07/2017

Quello che è stato ribattezzato fungo killer, ovvero Candida auris, riesce a sopravvivere e ad adeguarsi al notevole incremento delle temperature. Ecco spiegato il motivo per cui rispetto ad un gran numero di specie micotiche, con il passare del tempo avrebbero migliorato sempre di più l’abilità di infettare gli uomini.
A volte non ci diamo troppo peso, eppure la lotta ai cambiamenti climatici ha delle conseguenze importanti, visto che il riscaldamento globale porta a tutta una serie di effetti negativi che si riflettono anche sulla salute. Per questa ragione, le applicazioni appositamente sviluppate per smartphone, permettono di evitare sprechi nella quotidianità, riuscendo a contrastare meglio anche tutti questi fenomeni. Il boom delle app ha coinvolto anche altri settori, come ad esempio il gioco d’azzardo. Dando un’occhiata a una guida completa al gioco della roulette, si può intuire come anche chi gioca da dispositivi come smartphone e tablet possa vantare su un’offerta di gioco ampia e variegata.
Candida Auris: una recente indagine apre un nuovo capitolo sulla sua nascita
Il riscaldamento globale potrebbe essere la miccia che ha fatto esplodere la bomba della Candida auris, portando il fungo killer a diventare un vero e proprio problema di salute pubblica. Tra le principali caratteristiche di questo particolare fungo, troviamo un’impressionante resistenza rispetto alle cure farmacologiche e toglie la vita nel giro solamente di novanta giorni alle sue vittime. Secondo una recente indagine, che è stata poi pubblicata sulla rivista mBio, ci sarebbe un’importante correlazione tra il riscaldamento globale e la diffusione di questo fungo killer. Dal momento in cui è stato scoperto per la prima volta nel 2009, Candida Auris si sarebbe sviluppata contemporaneamente in Sud America, Sud Africa e India. La domanda che si fanno attualmente tutti i ricercatori è come questa nascita contemporanea in tre continenti diversi sia stata possibile. Ebbene, la colpa non sarebbe tanto del consumo eccessivo di antibiotici e antifungini, visto che l’emergenza potrebbe essere inquadrata da un’altra angolazione.Perché questi funghi sono così pericolosi
Riprendendo quanto evidenziato da un altro studio, pare che i cambiamenti del clima siano stati decisivi nel modificare lo sviluppo a livello ambientale del fungo killer, così come della sua capacità di infettare gli umani. E il fatto che tale fungo sia in grado di resistere senza particolari problemi all’aumento delle temperature conferma tale versione. Ed è proprio la capacità di adattarsi alle alte temperature rende questo fungo pericoloso per il corpo umano. Gran parte dei funghi, infatti, non è in grado assolutamente di sopravvivere alle temperature che caratterizzano il nostro corpo e, di conseguenza, il sistema di difesa del nostro organismo non ci mette poi molto per scacciarli. L’aspetto più preoccupante di tale indagine è che questo potrebbe essere solamente il primo passo verso una serie di problematiche sempre più evidenti e rischiose con la diffusione di funghi con tali caratteristiche, favorita dal riscaldamento globale. Mancano ancora le conferme ufficiali e serviranno ulteriori ricerche, ma ci sono veramente tantissimi indizi che spingono in tal senso.Articolo Precedente
Le destinazioni più belle da visitare in Canada
Articolo Successivo
FaceApp, l’app del momento mette a rischio la privacy
Redazione